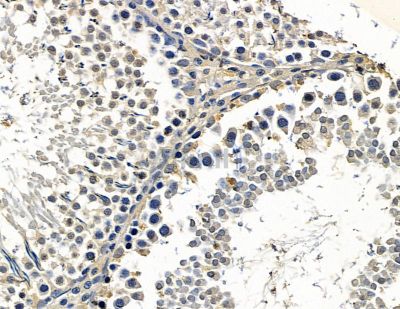
ZNF683 Antibody - DF15586 at 1/100 staining rat testis tissue by IHC-P.

ZNF683 Antibody - #DF15586
Related Downloads
Protocols
Product Info
*The optimal dilutions should be determined by the end user. For optimal experimental results, antibody reuse is not recommended.
*Tips:
WB: For western blot detection of denatured protein samples. IHC: For immunohistochemical detection of paraffin sections (IHC-p) or frozen sections (IHC-f) of tissue samples. IF/ICC: For immunofluorescence detection of cell samples. ELISA(peptide): For ELISA detection of antigenic peptide.
Fold/Unfold
MGC33414; RP11 569G9.6; Zinc finger protein 683; ZN683_HUMAN; ZNF 683; ZNF683;
Immunogens
A synthesized peptide derived from human ZNF683.
Expressed in terminally differentiated effector CD8(+) T-cells, but not in naive and central memory cells (PubMed:26179882). Expressed in terminally differentiated natural killer (NK) cells and natural killer (NKT) T-cells (at protein level) (PubMed:26179882). Expressed strongly in effector-type CD8(+) T-cells and weakly in naive and memory CD8(+) T-cells (PubMed:26179882). Expressed in terminally differentiated natural killer (NK) cells (PubMed:26179882). Isoform 2 is strongly expressed in effector CD8(+) T and natural killer (NK) cells (PubMed:26179882). Isoform 1 is expressed in effector CD8(+) T and natural killer (NK) cells (PubMed:26179882).
(Microbial infection) Expressed in cytomegalovirus (CMV)-infected effector CD8(+) T-cells (at protein level) (PubMed:20921622).
- Q8IZ20 ZN683_HUMAN:
- Protein BLAST With
- NCBI/
- ExPASy/
- Uniprot
MKEESAAQLGCCHRPMALGGTGGSLSPSLDFQLFRGDQVFSACRPLPDMVDAHGPSCASWLCPLPLAPGRSALLACLQDLDLNLCTPQPAPLGTDLQGLQEDALSMKHEPPGLQASSTDDKKFTVKYPQNKDKLGKQPERAGEGAPCPAFSSHNSSSPPPLQNRKSPSPLAFCPCPPVNSISKELPFLLHAFYPGYPLLLPPPHLFTYGALPSDQCPHLLMLPQDPSYPTMAMPSLLMMVNELGHPSARWETLLPYPGAFQASGQALPSQARNPGAGAAPTDSPGLERGGMASPAKRVPLSSQTGTAALPYPLKKKNGKILYECNICGKSFGQLSNLKVHLRVHSGERPFQCALCQKSFTQLAHLQKHHLVHTGERPHKCSIPWVPGRNHWKSFQAWREREVCHKRFSSSSNLKTHLRLHSGARPFQCSVCRSRFTQHIHLKLHHRLHAPQPCGLVHTQLPLASLACLAQWHQGALDLMAVASEKHMGYDIDEVKVSSTSQGKARAVSLSSAGTPLVMGQDQNN
Research Backgrounds
Transcription factor that mediates a transcriptional program in various innate and adaptive immune tissue-resident lymphocyte T-cell types such as tissue-resident memory T (Trm), natural killer (trNK) and natural killer T (NKT) cells and negatively regulates gene expression of proteins that promote the egress of tissue-resident T-cell populations from non-lymphoid organs. Plays a role in the development, retention and long-term establishment of adaptive and innate tissue-resident lymphocyte T cell types in non-lymphoid organs, such as the skin and gut, but also in other nonbarrier tissues like liver and kidney, and therefore may provide immediate immunological protection against reactivating infections or viral reinfection. Plays also a role in the differentiation of both thymic and peripheral NKT cells. Negatively regulates the accumulation of interferon-gamma (IFN-gamma) in NKT cells at steady state or after antigenic stimulation. Positively regulates granzyme B production in NKT cells after innate stimulation. Associates with the transcriptional repressor PRDM1/BLIMP1 to chromatin at gene promoter regions.
Lacks transcriptional repressor activity. Binds to DNA within promoter regions of the transcriptional repressor PRDM1/BLIMP1 target sites. Unable to regulate interferon-gamma (IFN-gamma) production in cytomegalovirus (CMV)-infected effector CD8(+) T-cells.
Transcriptional repressor that binds to DNA within promoter regions of the transcriptional repressor PRDM1/BLIMP1 target sites. Regulates interferon-gamma (IFN-gamma) production in cytomegalovirus (CMV)-infected effector CD8(+) T cells.
Nucleus.
Expressed in terminally differentiated effector CD8(+) T-cells, but not in naive and central memory cells. Expressed in terminally differentiated natural killer (NK) cells and natural killer (NKT) T-cells (at protein level). Expressed strongly in effector-type CD8(+) T-cells and weakly in naive and memory CD8(+) T-cells. Expressed in terminally differentiated natural killer (NK) cells. Isoform 2 is strongly expressed in effector CD8(+) T and natural killer (NK) cells. Isoform 1 is expressed in effector CD8(+) T and natural killer (NK) cells.
(Microbial infection) Expressed in cytomegalovirus (CMV)-infected effector CD8(+) T-cells (at protein level).
The C2H2-type zinc finger are necessary for DNA-binding (PubMed:26179882).
Belongs to the krueppel C2H2-type zinc-finger protein family.
Restrictive clause
Affinity Biosciences tests all products strictly. Citations are provided as a resource for additional applications that have not been validated by Affinity Biosciences. Please choose the appropriate format for each application and consult Materials and Methods sections for additional details about the use of any product in these publications.
For Research Use Only.
Not for use in diagnostic or therapeutic procedures. Not for resale. Not for distribution without written consent. Affinity Biosciences will not be held responsible for patent infringement or other violations that may occur with the use of our products. Affinity Biosciences, Affinity Biosciences Logo and all other trademarks are the property of Affinity Biosciences LTD.